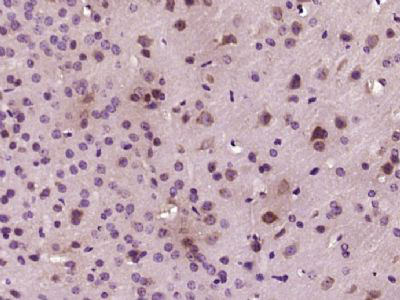
产品细节图片1

相关产品推荐更多 >
万千商家帮你免费找货
0 人在求购买到急需产品
- 详细信息
- 文献和实验
- 技术资料
- 供应商:
江西江蓝纯生物试剂有限公司
- 库存:
175
- 克隆性:
单克隆
- 保质期:
1年
- 抗体英文名:
PKC alpha
- 抗体名:
蛋白激酶C α抗体
- 适应物种:
人/动物/植物
- 应用范围:
WB,ELISA等
- 浓度:
1mg/ml
- 保存条件:
-20 °
- 规格:
100ul/200ul/50ul
| 规格: | 100ul | 产品价格: | ¥1580.0 |
|---|---|---|---|
| 规格: | 200ul | 产品价格: | ¥2480.0 |
| 规格: | 50ul | 产品价格: | ¥880.0 |
英文名称 : PKC alpha
中文名称 : 蛋白激酶C α抗体
别 名 : AAG6; Aging associated gene 6; KPCA_HUMAN; MGC129900; MGC129901; PICK 1; PKC A; PKC alpha; PKC alpha; PKC-A; PKC-alpha; PKCA; PRKACA; PRKC A; PRKCA; Protein Kinase C alpha; Protein kinase C alpha type.
研究领域 : 肿瘤 免疫学 信号转导 激酶和磷酸酶
抗体来源 : Rabbit
克隆类型 : Polyclonal
交叉反应 : Human, Mouse, Rat, Rabbit,
产品应用 : WB=1:500-2000 ELISA=1:500-1000 IHC-P=1:400-800 IHC-F=1:400-800 ICC=1:100-500 IF=1:100-500 (石蜡切片需做抗原修复)
not yet tested in other applications.
optimal dilutions/concentrations should be determined by the end user.
分 子 量 : 77kDa
细胞定位 : 细胞核 细胞浆 细胞膜
性 状 : Lyophilized or Liquid
浓 度 : 1mg/ml
免 疫 原 : KLH conjugated synthetic peptide derived from human PKC alpha:301-400/672
亚 型 : IgG
纯化方法 : affinity purified by Protein A
储 存 液 : 0.01M TBS(pH7.4) with 1% BSA, 0.03% Proclin300 and 50% Glycerol.
保存条件 : Store at -20 °C for one year. Avoid repeated freeze/thaw cycles. The lyophilized antibody is stable at room temperature for at least one month and for greater than a year when kept at -20°C. When reconstituted in sterile pH 7.4 0.01M PBS or diluent of antibody the antibody is stable for at least two weeks at 2-4 °C.
PubMed : PubMed
产品介绍 : Protein Kinase c alpha (PKC alpha) is an 77 kDa member of the conventional group (cPKCs: sensitive to calcium, diacylglycerol, phosphatidylserine and phorbol esters) of the PKC family of serine/ threonine kinases that are involved in a wide range of physiological processes including mitogenesis, cell survival and transcriptional regulation. PKC alpha is an ubiquitously expressed PKC isozyme that has been implicated in the regulation of a broad range of cellular functions including proliferation, differentiation, development, migration, cell cell adhesion, cell extracellular matrix adhesion, and solute transport. The activation loop threonine (threonine 497 in PKC alpha) of conventional PKCs is phosphorylated by phosphoinositide dependent kinase 1 (PDK1). This phosphorylation is necessary for the autophosphorylation of threonine 638 in the carboxy terminus of PKC alpha, a step that is critical for regulating the rate of PKC alpha dephosphorylation and inactivation.
Function:
Calcium-activated, phospholipid- and diacylglycerol (DAG)-dependent serine/threonine-protein kinase that is involved in positive and negative regulation of cell proliferation, apoptosis, differentiation, migration and adhesion, tumorigenesis, cardiac hypertrophy, angiogenesis, platelet function and inflammation, by directly phosphorylating targets such as RAF1, BCL2, CSPG4, TNNT2/CTNT, or activating signaling cascade involving MAPK1/3 (ERK1/2) and RAP1GAP. Involved in cell proliferation and cell growth arrest by positive and negative regulation of the cell cycle. Can promote cell growth by phosphorylating and activating RAF1, which mediates the activation of the MAPK/ERK signaling cascade, and/or by up-regulating CDKN1A, which facilitates active cyclin-dependent kinase (CDK) complex formation in glioma cells. In intestinal cells stimulated by the phorbol ester PMA, can trigger a cell cycle arrest program which is associated with the accumulation of the hyper-phosphorylated growth-suppressive form of RB1 and induction of the CDK inhibitors CDKN1A and CDKN1B. Exhibits anti-apoptotic function in glioma cells and protects them from apoptosis by suppressing the p53/TP53-mediated activation of IGFBP3, and in leukemia cells mediates anti-apoptotic action by phosphorylating BCL2. During macrophage differentiation induced by macrophage colony-stimulating factor (CSF1), is translocated to the nucleus and is associated with macrophage development. After wounding, translocates from focal contacts to lamellipodia and participates in the modulation of desmosomal adhesion. Plays a role in cell motility by phosphorylating CSPG4, which induces association of CSPG4 with extensive lamellipodia at the cell periphery and polarization of the cell accompanied by increases in cell motility. Is highly expressed in a number of cancer cells where it can act as a tumor promoter and is implicated in malignant phenotypes of several tumors such as gliomas and breast cancers. Negatively regulates myocardial contractility and positively regulates angiogenesis, platelet aggregation and thrombus formation in arteries. Mediates hypertrophic growth of neonatal cardiomyocytes, in part through a MAPK1/3 (ERK1/2)-dependent signaling pathway, and upon PMA treatment, is required to induce cardiomyocyte hypertrophy up to heart failure and death, by increasing protein synthesis, protein-DNA ratio and cell surface area. Regulates cardiomyocyte function by phosphorylating cardiac troponin T (TNNT2/CTNT), which induces significant reduction in actomyosin ATPase activity, myofilament calcium sensitivity and myocardial contractility. In angiogenesis, is required for full endothelial cell migration, adhesion to vitronectin (VTN), and vascular endothelial growth factor A (VEGFA)-dependent regulation of kinase activation and vascular tube formation. Involved in the stabilization of VEGFA mRNA at post-transcriptional level and mediates VEGFA-induced cell proliferation. In the regulation of calcium-induced platelet aggregation, mediates signals from the CD36/GP4 receptor for granule release, and activates the integrin heterodimer ITGA2B-ITGB3 through the RAP1GAP pathway for adhesion. During response to lipopolysaccharides (LPS), may regulate selective LPS-induced macrophage functions involved in host defense and inflammation. But in some inflammatory responses, may negatively regulate NF-kappa-B-induced genes, through IL1A-dependent induction of NF-kappa-B inhibitor alpha (NFKBIA/IKBA). Upon stimulation with 12-O-tetradecanoylphorbol-13-acetate (TPA), phosphorylates EIF4G1, which modulates EIF4G1 binding to MKNK1 and may be involved in the regulation of EIF4E phosphorylation. Phosphorylates KIT, leading to inhibition of KIT activity.
Subunit:
Recruited in a circadian manner into a nuclear complex which also includes BMAL1 and GNB2L1/RACK1 (By similarity). Interacts with ADAP1/CENTA1, CSPG4 and PRKCABP. Binds to SDPR in the presence of phosphatidylserine. Interacts with PICK1 (via PDZ domain). Interacts with TRIM41.
Subcellular Location:
Cytoplasm. Cell membrane; Peripheral membrane protein. Nucleus.
Similarity:
Belongs to the protein kinase superfamily. AGC Ser/Thr protein kinase family. PKC subfamily.
Contains 1 AGC-kinase C-terminal domain.
Contains 1 C2 domain.
Contains 2 phorbol-ester/DAG-type zinc fingers.
Contains 1 protein kinase domain.
SWISS:
P17252
Gene ID:
5578
Important Note:
This product as supplied is intended for research use only, not for use in human, therapeutic or diagnostic applications.
产品图片
风险提示:丁香通仅作为第三方平台,为商家信息发布提供平台空间。用户咨询产品时请注意保护个人信息及财产安全,合理判断,谨慎选购商品,商家和用户对交易行为负责。对于医疗器械类产品,请先查证核实企业经营资质和医疗器械产品注册证情况。
 文献和实验
文献和实验第五节 蛋白激酶C 蛋白激酶C(protein kinase C,PKC)是一类Ca 2+ 、磷脂依赖性的蛋白激酶,在跨膜信号传递过程中起着重要作用。PKC通过催化多种蛋白质上Ser/Thr磷酸化,调节多种细胞的代谢、生长、增殖和分化。 表 8-3 哺乳动物组织内的PKC亚类 亚 类 氨基酸残基 分子量(kDa) 激 活 剂 表达组织 A组:经典PKC
蛋白激酶C是G蛋白偶联受体系统中的效应物, 在非活性状态下是水溶性的,游离存在于胞质溶胶中,激活后成为膜结合的酶。蛋白激酶C的激活是脂依赖性的,需要膜脂DAG的存在,同时又是Ca2 依赖性的,需要胞质溶胶中Ca2 浓度的升高。当DAG在质膜中出现时,胞质溶胶中的蛋白激酶C被结合到质膜上,然后在Ca2 的作用下被激活。 同蛋白激酶A一样,蛋白激酶C属于多功能丝氨酸和苏氨酸激酶。蛋白激酶C能激活细胞质中的靶酶参与生化反应的调控, 同时也能作用于细胞核中的转录
广义的细胞色素 c是含有血红素 c的细胞色素之总称。通常是指主要存在于高等动植物、酵母、霉菌等线粒体中的细胞色素 c,起着传递电子的作用。为分子量约 1.3万的碱性蛋白质,还原型的吸收带为 550、 520、 415毫微米,氧化型为 407毫微米。α 因此很早便被研究,并获得结晶。不仅一级结构而且立体结构也已清楚(图 1)。其结构基本上是生物界共有的。由细胞色素 c氧化酶〔细胞色素( a+ a3 )复合体〕氧化。在呼吸链中从细胞色素 c开始接受电子,各种还原酶都已清楚
 技术资料
技术资料暂无技术资料 索取技术资料









